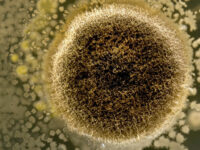
Mycoproteïne verlaagt cardiovasculaire ziektemarkers

Gezonde proefpersonen krijgen een beter cardiovasculair risicoprofiel als ze een deel van hun rood en bewerkt vlees uit hun voeding vervangen door mycoproteïne ofwel schimmeleiwit. Van rood en bewerkt vlees gaan de onderzoekers ervan uit dat minder beter is voor hart en vaten. Mycoproteïne zou bijzondere troeven bezitten voor het metabolisme. Aan de studie namen…
Lees meer
Lees meer